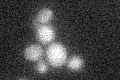
YHR194W
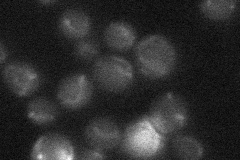
YHR194W
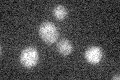
YHR194W

View description
Mitochondrial inner membrane protein with similarity to Mdm32p, required for normal mitochondrial morphology and inheritance; interacts genetically with MMM1, MDM10, MDM12, and MDM34
Localization:
Intensity:
Fold change:
Significance:
-
C’ GFP library in SD
below threshold17.49 -
N' NOP1pr-GFP in SD

mitochondria56.392 -
N' TEF2pr-mCherry in SD

mitochondria30.2112 -
N' NATIVEpr-GFP in SD
mitochondria20.8409 -
N' TEF2pr-VC and Cyto-VN in SD

#N/A0 -
C’ GFP library in SD+DTT

cytosol15.920.91No -
C’ GFP library in SD+H2O2

cytosol19.181.09No -
C’ GFP library in Starvation Media
cytosol14.430.82No -
C’ GFP library on the background of Pup2-DaMP

below threshold -
C’ GFP library on the background of CCT mutant

below threshold17.91871.02415No
